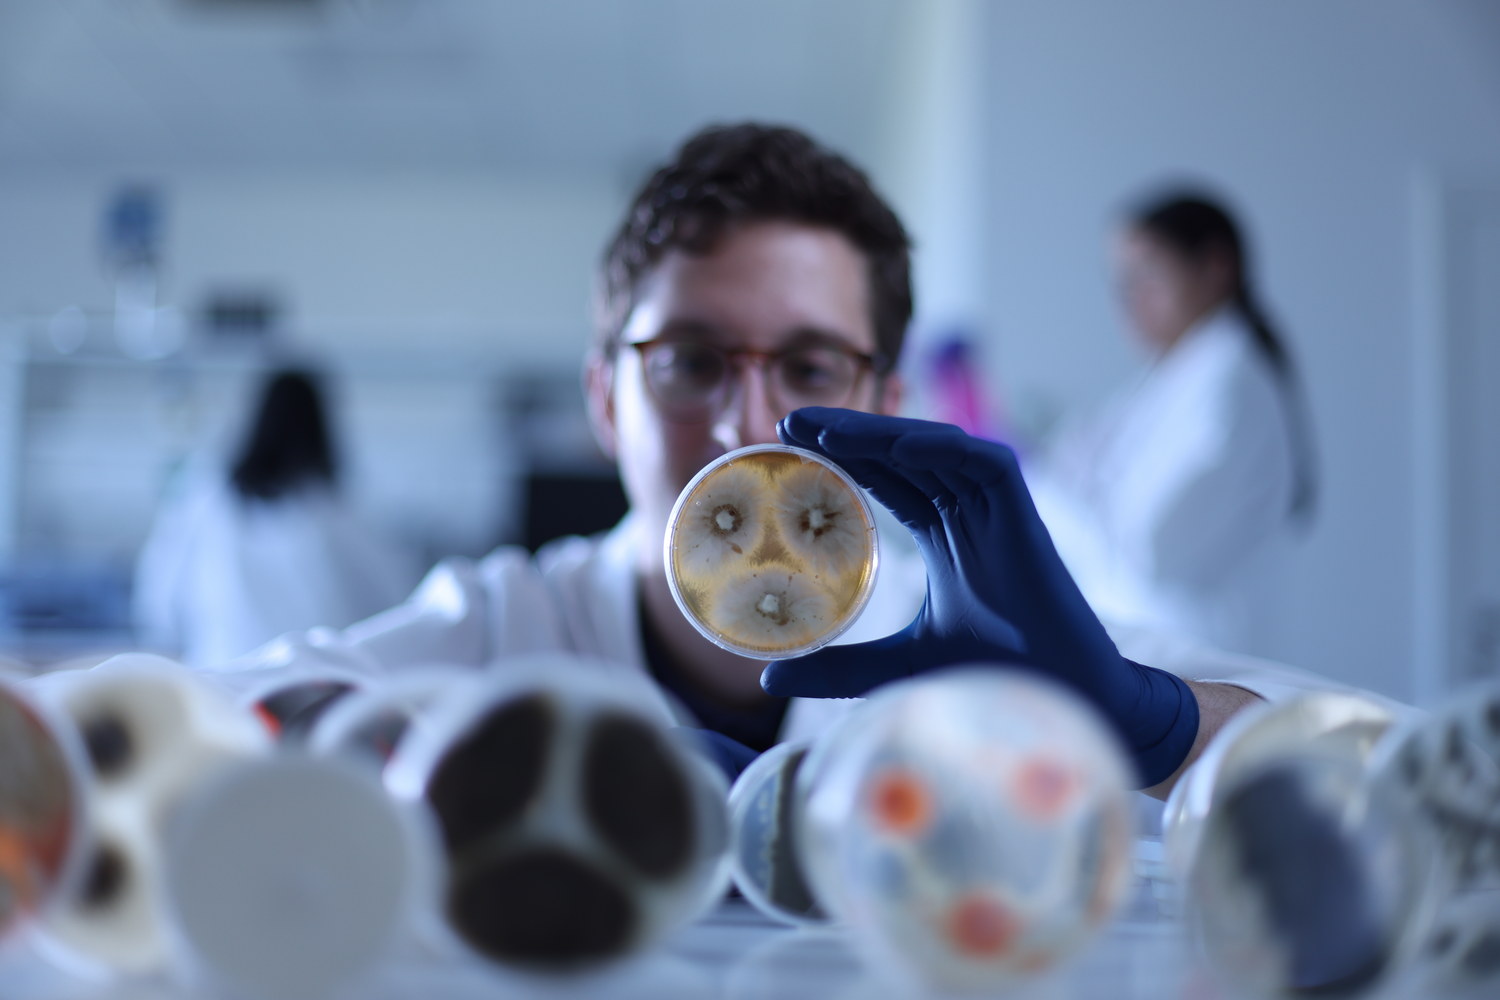
MR5_0299(1)

V sproščenem okolju Izole, enega najlepših obmorskih mest v Sloveniji, poteka razvoj presenetljivih inovacij. V starem središču mesta skupina raziskovalcev, ki jo podpira EU, razvija naravni gradbeni material, ki bi lahko spremenil naše stavbe.
Oglaševanje
Dr. Anna Sandak, glavna raziskovalka, je imela vizijo, ki se zdaj uresničuje. S podporo EU njena ekipa na oddelku InnoRenew CoE na Univerzi na Primorskem uporablja moč gliv za ustvarjanje živega, samoobnovljivega biofilma. Ta okolju prijazen premaz naj bi nadomestil konvencionalne, strupene materiale.
»Navdih za naše premaze črpamo iz narave, moč pa jim zagotavlja znanost,« pojasnjuje Anna. »Razvijamo namreč glivni biofilm za aktivno zaščito gradbenih materialov.«
V okviru petletne raziskovalne pobude ARCHI-SKIN s proračunom v višini skoraj 2 milijona evrov iz programa Horizon Europe v projektu sodeluje 13 članov iz 6 držav, ki prispevajo svoje znanje s področij mikrobiologije, biotehnologije in znanosti o materialih.

V želji, da bi domove naredili bolj zelene, ekipa raziskuje naravne materiale za gradnjo, da bi ustvarila resnično prilagodljivo in trajnostno arhitekturo. Tovrstno mednarodno sodelovanje je v skladu z merili EU za financiranje raziskav, saj povezuje strokovno znanje prek meja in spodbuja ustvarjalnost na področju znanstvenih inovacij. Poleg tega pomaga dosežke raziskav pretvoriti v dejansko vrednost, s čimer zagotavlja, da jih lahko ljudje in skupnosti dejansko uporabljajo in izkoristijo v resničnem življenju.
Podoktorska raziskovalka Anja Černoša poudarja, da so glive prave strokovnjakinje za odpornost: »Glive lahko uspevajo v različnih okoljih, zaradi česar so idealne za razvoj zdravju in okolju prijaznih izdelkov.«
Do leta 2027 namerava ekipa testirati popolnoma biološki premaz v realnih razmerah, s čimer bo zaznamovala novo obdobje trajnostne arhitekture s potencialnim vplivom po vsej Evropi in svetu.
Samo v Sloveniji je podpora EU za znanost spodbudila napredek v več kot 4800 raziskovalnih inštitutih, v katere je bilo od vstopa države v EU leta 2004 vloženo skoraj 1 milijardo evrov.
Že več kot 40 let EU podpira raziskave in znanost postavlja v središče svojih prizadevanj. Od čistejše energije do revolucionarnih rešitev na področju zdravstvenega varstva – prizadevanja EU niso omejena le na laboratorije.
V Izoli, kjer se laboratorij dobesedno stika z obalo, je očitno, da raziskovalci, ki jih podpira EU, prinašajo inovacije v resnični svet ter tako pomagajo oblikovati bolj zeleno in zdravo prihodnost za državljane.